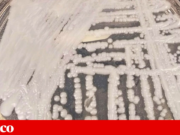
Estudo identifica os primeiros casos de Candida auris em Portugal e reforça importância da vigilância
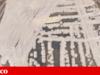
Estudo identifica os primeiros casos de Candida auris em Portugal e reforça importância da vigilância

Os deputados debateram cada artigo durante três dias e, na votação final global, o documento recebeu 37 votos a favor do Movimento para a Democracia (MpD), 24 votos contra dos deputados do Partido Africano da Independência de Cabo Verde (PAICV) e três votos contra da União Caboverdeana Independente e Democrática (UCID).
Nas declarações finais, o deputado João Santos Luís, da UCID, disse que apesar de “a economia apresentar sinais de estabilidade”, tal não se reflete “na mesa das famílias, no bolso dos trabalhadores, nem na esperança dos jovens, que continuam a abandonar o pais”.
João do Carmo, pelo PAICV, referiu que Cabo Verde “precisa urgentemente de um novo rumo”, numa alusão às eleições legislativas de 2026, com o partido a apresentar-se como “solução”, defendendo “um conceito de Estado amparo: o Estado deve amparar os que mais precisam”.
Celso Ribeiro, líder parlamentar do MpD, disse que o PAICV apresenta “propostas sem fundamentos”, numa altura em que Cabo Verde “está no rumo certo”, com um OE que “soube equilibrar prudência orçamental com visão social” e redução de impostos.
Olavo Correia, vice-primeiro-ministro com as pastas das Finanças e Economia Digital, fechou as intervenções, considerando que “os cabo-verdianos não querem ser amparados, querem oportunidades” e comparando as propostas do PAICV a uma ideia de “estado social no sentido comunista do termo, um regresso ao passado”.
O governante defendeu ainda que tem sido graças ao crescimento económico do país que tem sido possível aumentar salários a médicos, enfermeiros, professores e outros funcionários públicos, assim como reforçar os apoios sociais.
O OE 2026 ascende a 95,7 mil milhões de escudos (870 milhões de euros) e, a nível macroeconómico, prevê um crescimento do Produto Interno Bruto (PIB) de cerca de 6%, inflação em torno de 1,6%, taxa de desemprego de 7,3% e défice orçamental de 0,9% do PIB.
Quanto à dívida pública, a expectativa é que desça para 97,4% do PIB em 2026.
Na mesma sessão parlamentar, os deputados aprovaram ainda, por unanimidade, os orçamentos privativos da Comissão Nacional de Eleições (CNE) e da própria Assembleia Nacional para 2026.